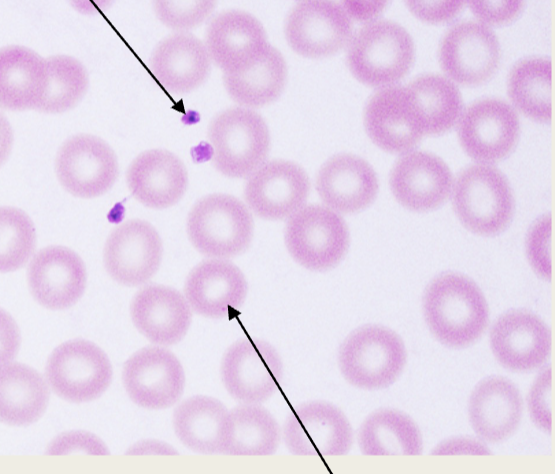
<p>What is the arrow at the top pointing to?</p>
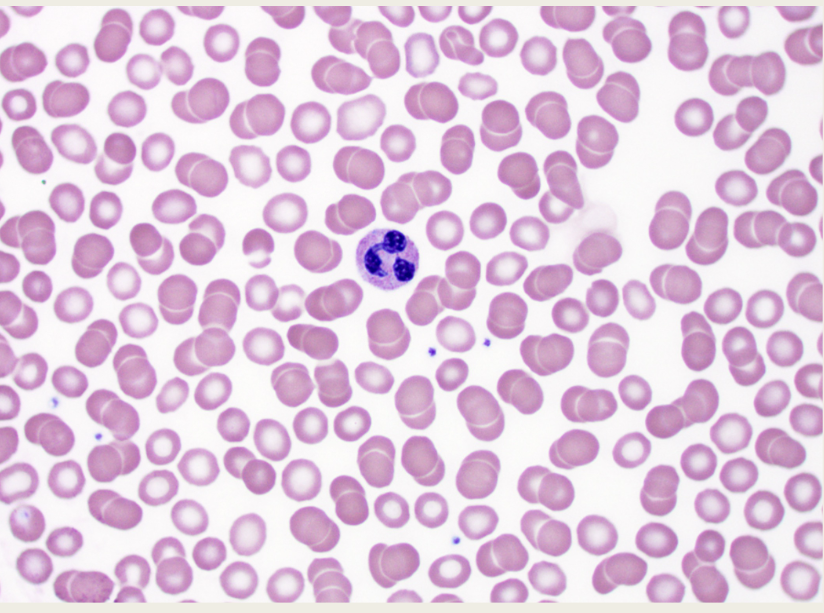
<p>What is this image of?</p>
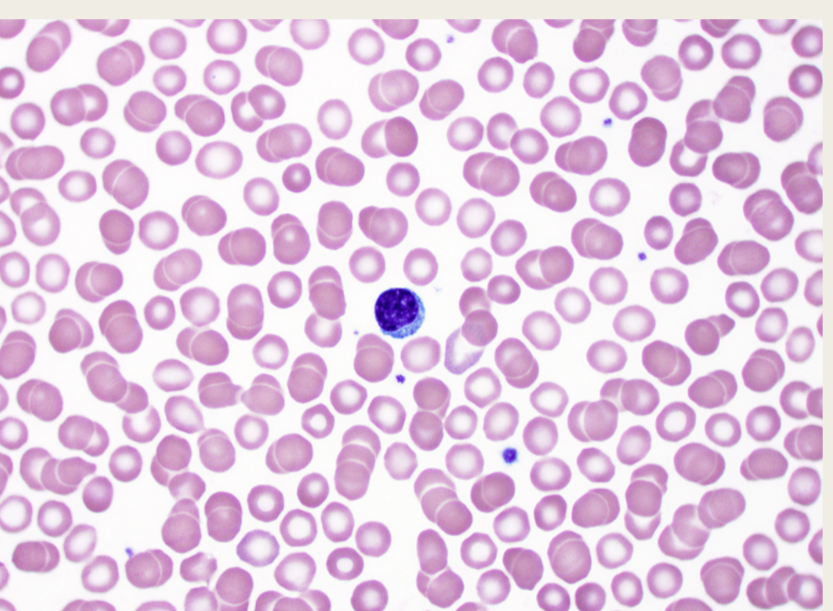
<p>What is this image of?</p>

Excercise 20
1/14
Earn XP
Description and Tags
Lab exam 3
Name | Mastery | Learn | Test | Matching | Spaced | Call with Kai |
|---|
No analytics yet
Send a link to your students to track their progress
15 Terms
Blood equals what
Connective Tissue
How much blood volume does formed elements take up?
45%
How much blood volume does plasma take up?
55%
What found in formed elements?
Red blood cells (RBC’s/ erythrocytes), White blood cell (WBC’S/ leukocytes) & platelets
What’s in plasma?
Water, lipids, dissolved substances, proteins, and clotting factors
Describe red blood cells
Most common blood cells, does not have a nucleus, and carries oxygen via hemoglobin
What is the arrow at the top pointing to?
Platelets

Whar is the arrow at the bottom pointing to?
Red blood cells, RBC’s
List the types of white blood cells, most common to least common
- Neutrophils
– Lymphocytes
– Monocytes
– Eosinophils
– Basophils
What’s a good way to remember the white blood cells, most common to leasr
Never Let Monsters Eat Babies
What is this image of?
Neutrophils
Describe Neutrophils
3-5 lobed nucleus, granular, normally the first to arrive at the site of an infection, ingest pathogens and release enzymes to kill microorganisms
What is this image of?
Lymphocytes
Describe Lymphocytes
one large, unlobed nucleus, agranular, smallest white blood cell, two types ( T cells and B cells)